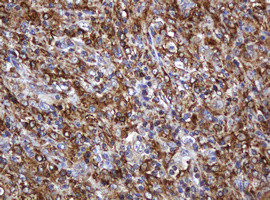
POGK Antibody in Immunohistochemistry (Paraffin) (IHC (P))

Search
OriGene
POGK Monoclonal Antibody (OTI3D2), TrueMAB™
{{$productOrderCtrl.translations['antibody.pdp.commerceCard.promotion.promotions']}}
{{$productOrderCtrl.translations['antibody.pdp.commerceCard.promotion.viewpromo']}}
{{$productOrderCtrl.translations['antibody.pdp.commerceCard.promotion.promocode']}}: {{promo.promoCode}} {{promo.promoTitle}} {{promo.promoDescription}}. {{$productOrderCtrl.translations['antibody.pdp.commerceCard.promotion.learnmore']}}
产品信息
TA505670
种属反应
宿主/亚型
分类
类型
克隆号
抗原
偶联物
形式
浓度
规格
纯化类型
保存液
内含物
保存条件
运输条件
靶标信息
This gene encodes a 134 kDa protein named strumpellin that is predicted to have multiple transmembrane domains and a spectrin-repeat-containing domain. This ubiquitously expressed gene has its highest expression in skeletal muscle. The protein is named for Strumpell disease; a form of hereditary spastic paraplegia (HSP). Spastic paraplegias are a diverse group of disorders in which the autosomal dominant forms are characterized by progressive, lower extremity spasticity caused by axonal degeneration in the terminal portions of the longest descending and ascending corticospinal tracts. More than 30 loci (SPG1-33) have been implicated in hereditary spastic paraplegia diseases.
仅用于科研。不用于诊断过程。未经明确授权不得转售。
篇参考文献 (0)
生物信息学
蛋白别名: KRAB box domain containing 2; Pogo transposable element with KRAB domain; unnamed protein product
基因别名: BASS2; KIAA1513; KRBOX2; LST003; POGK; SLTP003
UniProt ID: (Human) Q9P215
Entrez Gene ID: (Human) 57645